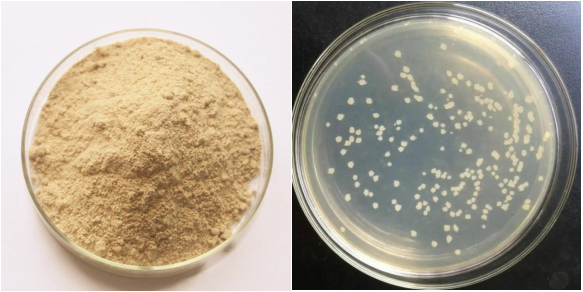

1.Product Features
Bacillus coagulans belongs to the genus Bacillus in taxonomy, with rod-shaped cells, Gram positive bacteria, terminal spores, and no flagella.2.Specifications

Improve meat quality of animal and aquaculture.


Ms Wendy Lee
Mobile&Wechat&Whatsapp : 0086 13562692198
Email :yuedongbiotech@aliyun.com
Ms Jeff Wang
Mobile&Wechat&Whatsapp : 0086 13563622867
Email :wfyuedong@aliyun.com
Ms Sundy Lee
Mobile&Wechat&Whatsapp : 0086 15965090376
Email :yuedongsundy@aliyun.com

